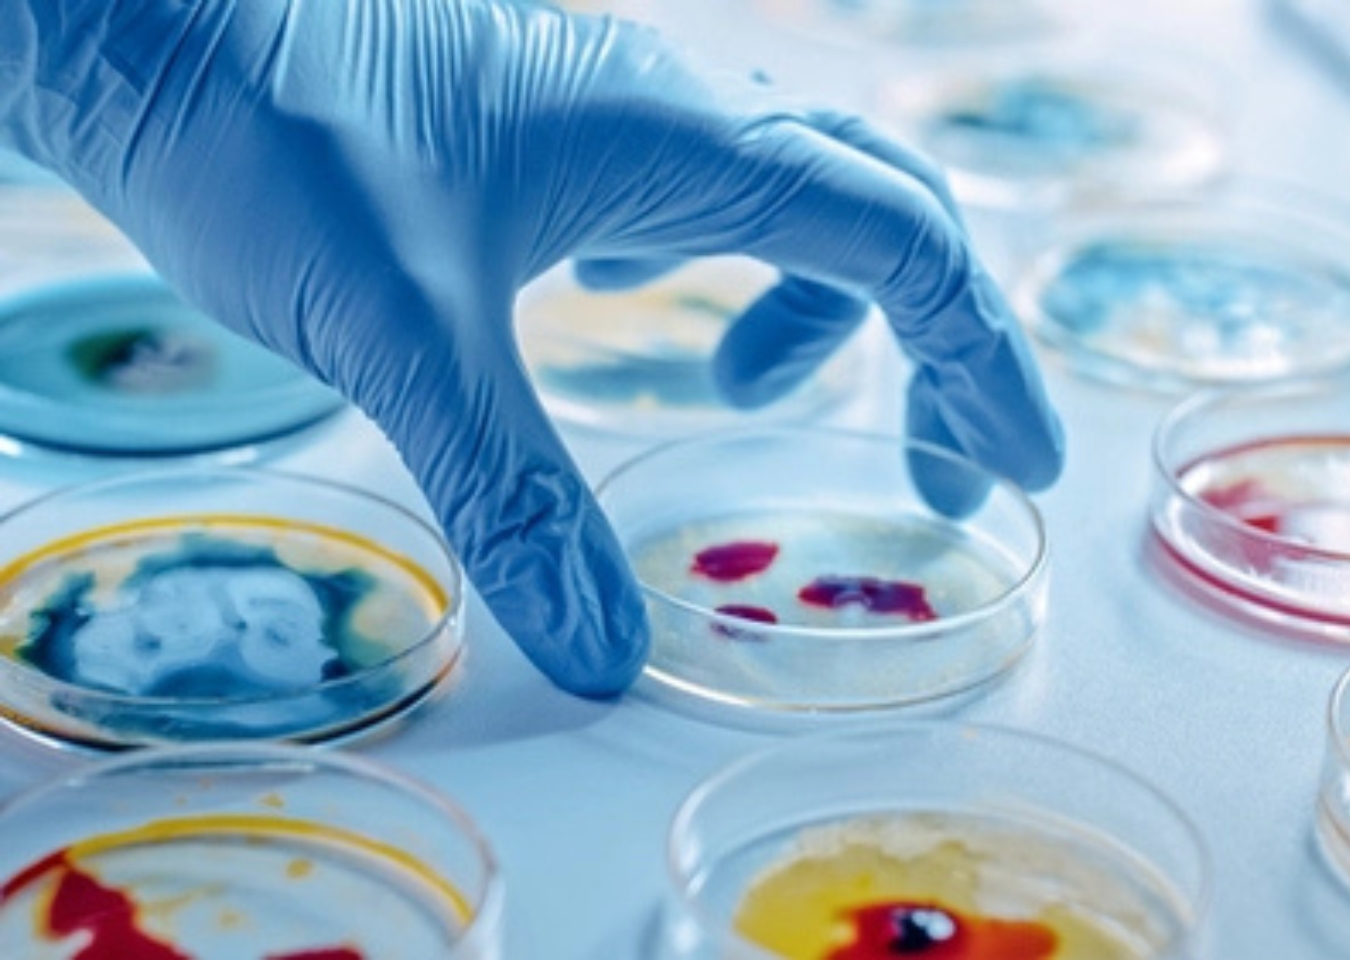
Vakuum aspirasjon

Applications for Welch Vacuum Pumps
Vacuum pumps from Welch are widely used in both laboratories and industry, covering a broad range of applications — here are some typical examples:
- Filtration and vacuum drying: The pumps remove gas or vapor from samples to enable fast and controlled drying.
- Gas sampling and analysis: They provide a stable vacuum for drawing gases through sensors or preparing samples for mass spectrometry.
- Laboratory and life science applications: For example, aspiration in cell culture, vacuum ovens, gel drying, and freeze-drying — Welch pumps can be used for all these purposes.
- Automation, pick & place, and vacuum fixturing: Providing vacuum to hold objects in place (vacuum workholding/vacuum chucking) or for automated handling.
- Industrial applications such as HVAC systems and process equipment: For example, removing air and moisture in cooling and ventilation systems.
Contact us
Contact us
We would like to hear from you if you have any questions or inquiries about our services and products!
Frode Rangset
on.te1763627423suhba1763627423l@edo1763627423rf1763627423
+47 94826016